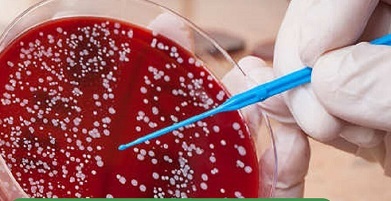

شفاآنلاین »سلامت» خون بندناف که منبعی غنی از سلولهای بنیادی است تا همین چند سال قبل راهی سطل زباله و به عنوان یک زباله بیولوژیک امحا میشد. با اینکه سلولهای بنیادی خونساز موجود در خون بند ناف، ظرفیت درمان انواع بسیاری از اختلالات ایمنی و بدخیمیهای خونی اطفال را دارد، این منبع ارزشمند از دست میرفت. نظر به اهمیت این خون در درمان بیماریها، 17 نوامبر به عنوان روز جهانی خون بند ناف نامگذاری شده است. به گفته مدیرعامل بانک خون بند ناف رویان، کشورمان رتبه اول در حوزه ذخیرهسازی خون بند ناف در منطقه و غرب آسیا را دارد و جزو سه کشور برتر و پیشرو در این زمینه به شمار میرود.
به گزارش شفاآنلاین به همت متخصصان داخلی، شرکت فناوری بنیاختههای رویان در سال 1384 با هدف تأمین سلولهای بنیادی موردنیاز مراکز پیوند راهاندازی شد و امروز 250 هزار نمونه خون بند ناف در رویان ذخیرهسازی شده است. دکتر مرتضی ضرابی، مدیرعامل بانک خون بند ناف رویان میگوید: « سلول بنیادی، سلولی مادر است که میتواند به سلولهای تخصصی تبدیل شود. این سلولها دو نوع خونساز و غیرخونساز (مزانشیم) دارند.
سلولهای بنیادی خونساز در خون محیطی، مغز استخوان و خون بند ناف وجود دارد. کاربرد این سلولها در بیماریهای خونی است و سلولهای غیرخونساز در فلج مغزی و سایر مشکلات و بیماریها کاربرد دارد. ضمائم زایمانی نیز شامل سرم خون بند ناف، بافت بند ناف، پردههای جنینی و پلاسمای غنی از پلاکت (پیآرپی) است.» ضرابی در پاسخ به این سؤال که آیا خون بند ناف فقط برای همان کودک و تا سن خاصی قابل مصرف است، توضیح میدهد: «خون بند ناف بین 80 تا 150 سیسی است و در هر فرد ممکن است تعداد سلول هم متفاوت باشد. در هر نمونه خون بند ناف ممکن است از 600 میلیون تا بیش از 2 میلیارد سلول وجود داشته باشد. البته حجم این سلولهای ذخیرهسازی شده بسته به طول بند ناف، اندازه جفت، نوع زایمان حجمهای مختلفی دارد. بنابراین تعداد سلولهای بنیادی با توجه به اینکه ما چه تعداد سلول را جمعآوری میکنیم، متفاوت است.
معمولاً این نمونه را در یک کیسه یا دو کیسه فریز میکنیم و قاعدتاً از هر کیسه برای هر نوبت پیوند استفاده میشود. اگر یک نمونه در یک کیسه فریز شده باشد برای یک نوبت و اگر در دو کیسه فریز شده باشد برای دو نوبت قابل استفاده خواهد بود.» ضرابی با بیان اینکه امکان تکثیر سلولهای خون بندناف وجود ندارد، توضیح میدهد: «ما هر نمونهای که ذخیرهسازی میکنیم مشخصاً به همان حجم و تعدادی که هست برای بیمار قابل استفاده است. ولی سلولهای بنیادی بند ناف یا سلولهای غیر خونساز که به «مزانشیم» معروفند، امکان تکثیر دارند. برای همین از یک بند ناف شاید بتوانیم برای 20 کودک مبتلا به فلج مغزی سلولی که از این جداسازی تکثیر کردهایم، استفاده کنیم. این تفاوت دو مورد است ولی از نظر استفاده فقط برای یک نوبت قابل استفاده است.» مدیرعامل بانک خون بند ناف در ادامه با بیان اینکه اصولاً سلولهای بنیادی خونساز اگر بخواهند پیوند شوند باید حتماً تطابق ژنتیکی داشته باشند، میگوید: «فرد دهنده و فرد گیرنده باید از نظر ژنتیکی یا اصطلاحاً «اچ ال ای» با یکدیگر تطبیق داشته باشند.
به همین دلیل است که وقتی مثلاً فردی مبتلا به بیماری سرطان است در مرحله اول تطابق ژنتیکی، سراغ برادر، خواهر، پدر و مادر و بستگان نزدیک او میرویم تا اگر تطابق ژنتیکی داشتند، بتوانیم از فرد سالم نمونه بگیریم. در مورد نمونه خون بند ناف هم تفاوت در این است که در نمونه خون بند ناف، فردی که صد درصد با نوزادی که نمونهاش ذخیرهسازیشده تطبیق دارد میتواند از آن نمونه استفاده کند که شامل خود کودک و کسانی که با او تطابق ژنتیکی دارند، میشود.» او با بیان اینکه بیش از 50 درصد موارد خواهر و برادر از نظر تطابق ژنتیکی با هم یکی هستند، توضیح میدهد: «بهجز این در کشورمان بسیاری از افراد هستند که با همدیگر تطبیق ژنتیکی دارند. ما بیماری داشتیم از مشهد که یک نمونه از استان کرمانشاه برای او پیدا شد که تطبیق داشت و پیوندش را انجام دادیم. یک بانک اطلاعات ژنتیکی داریم که نمونهها را میتوانیم با هم تطبیق دهیم. یعنی اگر بیماری به ما مراجعه کند، میتوانیم در بانک جستوجو کنیم که نمونه منطبق با آن بیماری موجود هست یا نه، اگر وجود داشته باشد به مرکز پیوند اعلام میکنیم نمونه منطبق وجود دارد. البته ممکن است بگویید، این نمونه که متعلق به خانوادههاست ما که نمیتوانیم به افراد دیگر بدهیم، نمونههایی که در بانک عمومی داریم در اختیار خودمان است، میتوانیم به افرادی که نیاز دارند از این بانک نمونه بدهیم یا از نمونههای بانک خصوصی که اهدا شدهاند، استفاده کنیم. نکته مهم این است که خوشبختانه حدود 35 درصد از کسانی که به بانک خصوصی نمونههایی اهدا کردهاند، رضایتشان را اعلام کردهاند که اگر زمانی کودک یا بیمار به سلول بنیادی و نمونه آنها نیاز داشت و این نمونه برای آنها قابل استفاده بود به آنها اطلاع دهیم و از نمونه ذخیرهشدهشان استفاده کنیم. بنابراین از نمونههای اهدایی و نمونههای بانک عمومی به شرط اینکه تطابق ژنتیکی داشته باشد، میتوانیم برای افراد دیگر استفاده کنیم.»
ضرابی با اشاره به اینکه هزینه نگهداری سالانه خون بندناف در بانک خصوصی حدود 750 هزار تومان است، در مورد اینکه سالانه چه تعداد افراد به دلیل پیدا نشدن نمونه «اچ ال ای» جانشان را از دست میدهند، میگوید: «تقریباً 70 درصد کسانی که به سلول بنیادی خنثی نیاز دارند، دهنده مناسب پیدا نمیکنند. یعنی این افراد برای اینکه نمونه مناسب برای پیوندشان پیدا شود به لیستهای انتظار میروند. بنابراین هر چقدر بتوانیم ذخیره سلولهای بنیادی را افزایش دهیم و امکان تبادل نمونه با سایر کشورها فراهم شود، شانس پیوند و پیدا شدن نمونه مناسب در افراد هم بالاتر خواهد رفت.» مدیرعامل بانک خون بند ناف در مورد هزینه گرفتن نمونه از بانک جهانی میگوید: «دریافت هر نمونه از بانک جهانی بسته به اینکه ژنتیک آن چقدر به نوعی کمیاب و نادر است بین 30 تا 40 هزار یورو هزینه دارد، حتی مواردی هم بوده که60 هزار یورو هزینه شده است.»
ضرابی در مورد حمایت از اهداکنندگان خون بند ناف به بانک عمومی هم توضیح میدهد: «افراد با اهدای نمونه یک کارت اهدا دریافت میکنند. اگر در آینده خودشان به سلول بنیادی نیاز داشته باشند، اگر نمونهای که قبلاً خودشان اهدا کرده بودند در بانک بود، میتوانند از نمونه خودشان استفاده کنند. اگر نمونه نبود از نمونههای اهدایی بانک در اختیارشان قرار میدهیم.»
مدیرعامل بانک خون بند ناف رویان با اشاره به دستاوردهای بیست ساله این مرکز تأکید میکند: «راهاندازی بانک سلولهای بنیادی خون بند ناف، خون محیطی، مغز استخوان، بافت بند ناف، پالپ دندان، پیوند سلولهای بنیادی در بیماران خونی، ارتوپدی، عصبی و انجام کارآزماییهای بالینی در زمینه استفاده از سلولهای بنیادی بند ناف در فلج مغزی، اوتیسم، آرتروز و ایالاس نیز انجام شده است. ساخت اولین پالایشگاه محصولات زایمانی و راهاندازی بزرگترین بانک اطلاعات ژنتیکی با 100 هزار دیتا نیز از جمله دستاوردهایی است که در 20 سال گذشته داشتهایم.»
او با بیان اینکه ایران بزرگترین بانک سلولهای بنیادی خون بند ناف را در منطقه دارد و این بانک خون بند ناف به دو بخش عمومی و خصوصی تقسیم شده است، میگوید: «مهمترین اقدامی که در این شرکت انجام شده راهاندازی بانک سلولهای بنیادی خون بند ناف بوده که خون بند ناف از سراسر کشور جدا میشود و در تانکهای نیتروژن در منفی 96 درجه نگهداری میشود. در بانک خصوصی، خون بند ناف برای خانوادههایی که اهداکننده هستند، ذخیره میشود. در این بانک 250 هزار نمونه خون بند ناف وجود دارد و در بانک عمومی نیز خون بند ناف اهدا میشود و تاکنون 5 هزار نمونه ذخیره شده است. سالانه نزدیک به 25 هزار نمونه توسط خانوادهها به بانک خصوصی ارائه میشود و امیدواریم با کمک دولت و خیرین ذخایر بانک خون بند ناف عمومی را نیز توسعه دهیم.» ضرابی با تأکید بر اینکه در حوزه ملی بزرگترین، معتبرترین و پیشروترین مرکز ذخیرهسازی سلولهای بنیادی خون بند ناف هستیم، میگوید: «در کل کشور 46 دفتر نمایندگی داریم که جمعآوری خون بند ناف را مطابق با استانداردهای بینالمللی انجام میدهند. ما جزو سه مرکز برتر و پیشرو در حوزه ذخیرهسازی خون بند ناف در منطقه هستیم و از نظر حجم عملیات، تجربه بالینی و پوشش ملی جزو سه کشور برتر منطقه به شمار میآییم. براساس حجم ذخیرهسازی و دامنه فعالیتهای تجاری بینالمللی به لحاظ تعداد نمونههای ذخیره شده، رویان رتبه دوم را در جهان دارد.»
ضرابی با بیان اینکه نمونههای ذخیرهسازی شده باعث شده تا 40 بیمار خونی (تالاسمی، سرطان خون، نقص ایمنی و کمخونی) و 60 بیمار عصبی (فلج مغزی و اوتیسم) پیوند سلولی دریافت کنند، توضیح میدهد: «در بیماریهای خونی 80 درصد موفقیت پیوند داشتهایم و در بیماریهای عصبی نیز درجاتی از موفقیت حاصل شده است.»
او بانک خون محیطی و مغز استخوان را یکی دیگر از بانکهای درحال فعالیت این مرکز عنوان میکند و میگوید: «خدمات بانک خون محیطی برای مراکز پیوند برای بیماران مبتلا به سرطان خون مورد استفاده قرار میگیرد و تاکنون حدود 900 بیمار پیوند دریافت کردهاند. ما یک طرح تحقیقاتی بسیار بزرگ برای 150 کودک دچار فلج مغزی انجام دادهایم و برای آنها پیوند انجام شد. همچنین امکان ارائه خدمات برای درمان کودکان مبتلا به فلج مغزی با استفاده از سلولهای بنیادی بند ناف فراهم شده و کودکان مبتلا میتوانند از این فناوری نوین استفاده کنند. همچنین طی یک کارآزمایی استفاده از سلولهای بنیادی در درمان آرتروز انجام شد و اولین سلول مشتق از بافت بند ناف در فهرست دارویی کشور درج شده است و امکان ارائه خدمات درمانی به بیماران مبتلا به آرتروز مفاصل وجود دارد.»